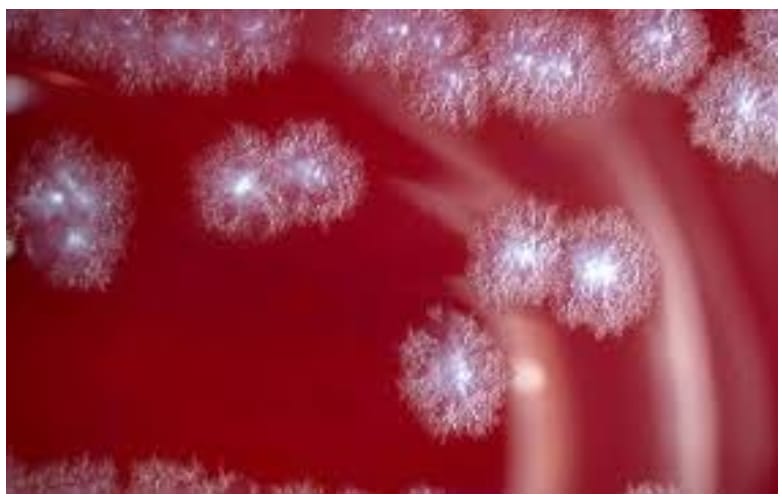

En los laboratorios contemporáneos se está gestando una idea que parece salida de una fábula microscópica: bacterias diseñadas para devorar tumores desde dentro. No es una metáfora médica. Es biología sintética.
Durante décadas la medicina enfrentó el cáncer, de manera genérica o específica, como si fuera a la guerra. Los tumores se atacaban, las células malignas se combatían, los tejidos cancerosos se bombardeaban. Una metáfora que ha servido para expresar la seriedad del desafío. Sin embargo, en algunos laboratorios del mundo, se está adoptando otra estrategia. Ya no se le ataca frontalmente utilizando todos los arsenales permitidos por la medicina. Ahora se le somete a un procedimiento más silencioso y sutil, por medio del cuál es devorado lentamente. Una escena más biológica que militar. En lugar de las armas tecnológicas, se utilizan bacterias. Microorganismos cuidadosamente diseñados por científicos para alimentarse de tumores desde su interior.
Un equipo de investigadores de la Universidad de Waterloo ha propuesto transformar una bacteria común del suelo, Clostridium sporogenes, en una herramienta terapéutica capaz de colonizar tumores y consumirlos desde dentro. La idea combina microbiología, ingeniería genética y biología sintética, produciendo resultados que hace apenas medio siglo habrían parecido ciencia ficción.
La elección de esta bacteria no es casual. La Clostridium sporogenes posee una característica que en el mundo natural resulta limitante, pero en el contexto del cáncer se vuelve extraordinariamente útil: sólo puede vivir en ambientes sin oxígeno. Los tumores sólidos desarrollan regiones centrales donde el oxígeno escasea o desaparece por completo. En esas zonas, llamadas regiones hipóxicas, se acumulan células muertas, residuos metabólicos y nutrientes mal aprovechados. Se transforman en bunker para el cáncer, pues los fármacos penetran mal y la radioterapia pierde eficacia.
Cuando las esporas de Clostridium sporogenes entran en un tumor, germinan y comienzan a multiplicarse. Encuentran nutrientes, ausencia de oxígeno y un entorno propicio para crecer. El tumor se convierte en su alimento. La bacteria coloniza el centro del tejido canceroso y empieza a consumirlo. El cáncer ha sido descrito como una entidad que devora el cuerpo desde dentro. Aquí ocurre que algo más pequeño devora al devorador. Hay que admitir la belleza del sarcasmo.
=> Recibir por Whatsapp las noticias destacadas
Sin embargo, no es una técnica perfecta. La bacteria prospera en el núcleo del tumor, pero muere cuando alcanza sus bordes. Allí vuelve a aparecer el oxígeno, que resulta tóxico para ella. El microorganismo puede colonizar el corazón del tumor, pero no siempre logra destruirlo por completo.
La solución que imaginaron los investigadores fue rediseñar organismos vivos incorporando genes de distintas especies, ensamblándolos como si se tratara de componentes de una máquina. Los científicos añadieron a la bacteria un gen proveniente de otro microorganismo que puede tolerar mejor el oxígeno. Con esa modificación, Clostridium sporogenes podría sobrevivir más tiempo en las zonas externas del tumor.
Pero el problema no termina ahí. Si ese gen se activara demasiado pronto, la bacteria podría sobrevivir fuera del tumor, incluso en el torrente sanguíneo o en tejidos sanos. La terapia perdería precisión. Entonces, para evitarlo, los investigadores recurrieron a un mecanismo fascinante que ya existe en la naturaleza bacteriana: la llamada detección de quórum, o quorum sensing.
El sistema funciona como un circuito biológico. De hecho, los investigadores describen su trabajo como un ensamble de fragmentos de ADN, casi como si fueran cables en un circuito eléctrico. Cada pieza cumple una función y, cuando se combinan correctamente, el conjunto produce un comportamiento predecible.
Este tipo de investigación revela un cambio cultural profundo en la medicina. Durante gran parte del siglo XX, las bacterias fueron vistas como enemigas. Como parte de esa guerra por la sanidad. El desarrollo de los antibióticos consolidó esa imagen. Se pensó el progreso médico como una misión contra los microorganismos.
Hoy sabemos que el cuerpo humano alberga trillones de bacterias que cumplen funciones esenciales para la digestión, el sistema inmunológico e incluso la regulación del estado de ánimo. El descubrimiento del microbioma cambió nuestra forma de entender la vida humana. Con la biología sintética damos un paso más allá. No sólo convivimos con bacterias, podemos diseñarlas para realizar tareas específicas.
A fin de cuentas, pareciera que la medicina en particular, y la humanidad en general, ha entendido que la vida, incluso en su escala más pequeña, siempre encuentra formas de reorganizar el equilibrio. Quizás el futuro de la medicina esté en aprender a dirigir los procesos invisibles que ya ocurren en la naturaleza. Incluso aquellos que suceden en el silencio microscópico de una bacteria que se alimenta de nuestro enemigo.
Por Mauricio Jaime Goio.